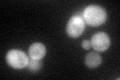
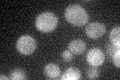

View description
Ser/Thr protein kinase that regulates the putative phospholipid translocases Lem3p-Dnf1p/Dnf2p; phosphorylates and inhibits upstream inhibitory kinase, Ypk1p; localizes to the cytoplasm, early endosome/TGN compartments, and plasma membrane
Localization:
Intensity:
Fold change:
Significance:
-
C’ GFP library in SD

cytosol29.71 -
N' NOP1pr-GFP in SD

cytosol,punctate61.9157 -
N' TEF2pr-mCherry in SD

cytosol60.5883 -
N' NATIVEpr-GFP in SD

cytosol29.7575 -
N' TEF2pr-VC and Cyto-VN in SD

#N/A0 -
C’ GFP library in SD+DTT
cytosolN/AN/ANo -
C’ GFP library in SD+H2O2

cytosolN/AN/ANo -
C’ GFP library in Starvation Media
cytosolN/AN/AYes -
C’ GFP library on the background of Pup2-DaMP

cytosol -
C’ GFP library on the background of CCT mutant

cytosolN/AN/ANo
